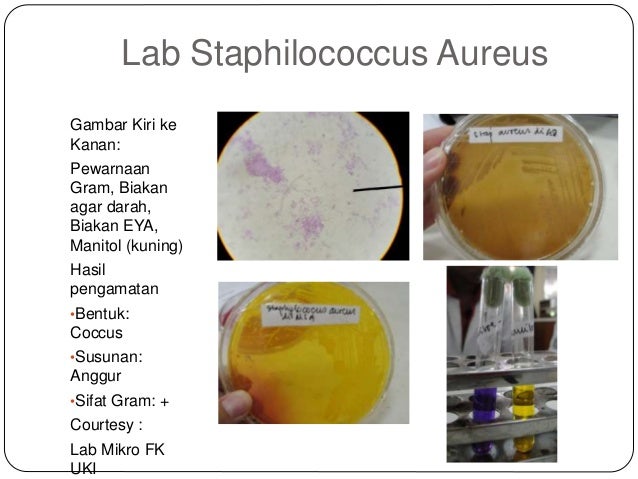

45+ Info Terpopuler Kalung Emas Kecil
Desember 18, 2020
Kalung Emas Kecil Elegan, Kalung Emas Kecil Cantik, Harga Kalung Emas Kecil, Kalung emas kecil simple, Kalung Emas Kecil Tipis, Kalung Emas Tipis kecil dan Cantik, Kalung Emas Rantai Kecil, Kalung Kecil Simple, Model Kalung Emas, Kalung emas putih, Harga kalung emas Anak Kecil 1 gram, Kalung Kecil Tipis,
45+ Info Terpopuler Kalung Emas Kecil - Semakin berkembangnya trend style yang populer saat ini dan melahirkan bermacam-macam gelang unicorn tentu kamu akan sedikit merasa kebingungan model mana yang pantas untuk menunjang penampilan. Tentu kamu mengharapkan penampilan yang paling maksimal untuk menghadiri berbagai acara baik itu acara formal semi resmi maupun momen santai. Sudah menjadi rahasia umum andaikata kalung emas kecil merupakan salah satu model pakaian yang menjadi andalan untuk tetap tampil mempesona.
Nah, pada kesempatan kali ini kami akan mencoba untuk memberikan pada kalian pecinta fashion beberapa inspirasi tentang gelang unicorn yang tentunya telah kami pilih sesuai dengan gaya fashion masa kini yang up todate, dengan fokus pembahasan 45+ Info Terpopuler kalung emas kecil.Langsung saja simak berbagai gambar inspirasi tentang gelang unicorn dengan judul 45+ Info Terpopuler kalung emas kecil yang tentunya menarik perhatian kamu.

10 Perhiasan Perunggu Sebagai Alternatif Aksesori untuk . Sumber Gambar : bp-guide.id
Jual Kalung Emas Murah Harga Terbaru 2021
Kalung Emas Italy Biji Lada Kecil Rosegold Frank n co Original Necklac Rp5 332 750 Jakarta Pusat Toko Online Jempol 4 Tambah ke Wishlist Kalung Emas C122 Gold Flat Curb Chains Rp26 000 Kab Gianyar Eba Grab Your Wishes 1 Tambah ke Wishlist
Impetigo Bullosa . Sumber Gambar : www.slideshare.net
Jual Kalung Emas 5 Gram Murah Harga Terbaru 2021
Beli Kalung Emas 5 Gram Online berkualitas dengan harga murah terbaru 2021 di Tokopedia Pembayaran mudah pengiriman cepat bisa cicil 0

Saga rambat cantik tapi beracun . Sumber Gambar : naufalbear.blogspot.com
Jual Kalung Emas Anak Terbaru dan Terlengkap Blibli com
Jual Kalung Emas Anak Model Terbaru Beli Kalung Emas Anak Pasti Senang karena Bentuknya yang Unik Perhiasan maupun aksesoris bisa membuat penampilan jadi makin oke Ya tentu saja karena aksesori yang menarik bisa menjadikan penampilan penggunanya jadi lebih menarik Emas adalah salah satu bahan perhiasan atau aksesori paling berharga

Bilik Imut Frame Foto Dari Kardus . Sumber Gambar : bilikimut.blogspot.com
Katalog Harga Kalung Terlengkap November 2021 di Indonesia
Lingkaran kecil tersebut saling berhubungan satu sama lain untuk mengingatkan bahwa apa yang kita dapatkan kelak sesuai dengan apa yang kita lakukan saat ini Kalung ini terbuat dari 14k emas vermeil Cara Merawat Kalung Perak Agar Tetap Awet Tren perhiasan kalung perak saat ini semakin luas di masyarakat dunia termasuk di Indonesia

Maharum Bugis Syah MBS Istiadat Kemahkotaan Sultan . Sumber Gambar : tengkusyah.blogspot.com
6 Model Kalung Emas 24 Karat Terbaru Update 2021
5 10 2021 Kalung emas 24 karat model pertama yaitu model polos Sesuai dengan namanya kalung emas 24 karat satu ini memang memiliki desain yang simpel dilengkapi dengan bandul kecil yang berkilau Memang sih beberapa orang berpendapat bahwa kalung emas 24 karat model polos ini merupakan model yang jadul dan sudah ketinggalan zaman

Serba Serbi Tradisi Pernikahan Adat Bugis Makasar . Sumber Gambar : mahligai-indonesia.com
6 Model Kalung Emas Terbaru dan Terpopuler untuk Millenial
11 3 2021 Dalam penggunaannya kalung inisial nama ini bisa dipakat sehari hari atau dalam acara formal sekalipun Biasanya sebagai pemanis di liontin inisial akan dihiasi dengan berlian berlian kecil yang menonjolkan hurufnya Kalung liontin mutiara Salah satu model kalung emas yang harus dimiliki ialah kalung emas yang dihiasi dengan mutiara

RANDOM Resensi Novel Hafalan Sholat Delisa . Sumber Gambar : annisadianziziani.blogspot.com
Wayang Rama Jogja . Sumber Gambar : www.hadisukirno.co.id
TAFSIR MIMPI 4D NAIRASAON . Sumber Gambar : nairasaon.club
Wayang Kumbakarna Solo . Sumber Gambar : www.hadisukirno.co.id
Fiberglass Sandblasting Etsa kaca Emboss Digital . Sumber Gambar : sablonfrosted1.blogspot.com

Pelatihan Pendidikan Lpk Diklat Belajar Kursus Les . Sumber Gambar : kursusmodern.blogspot.com
Wayang Limbuk Jogja . Sumber Gambar : www.hadisukirno.co.id
Wayang Sengkuni Jogja . Sumber Gambar : www.hadisukirno.co.id
Wayang Sadewa Jogja . Sumber Gambar : www.hadisukirno.co.id
Wayang Antareja Solo . Sumber Gambar : www.hadisukirno.co.id
PENDIDIKANHOT KEBUDAYAAN YANG BERASAL DARI JAWA BARAT . Sumber Gambar : pendidkanhot.blogspot.com

saskiasyam LEGENDA OBJEK WISATA GOWA 14 Mei 2021 . Sumber Gambar : saskiasyam.wordpress.com
Jenis 24 jam Hours Perlis Kedah Perak Langkawi . Sumber Gambar : sewa-lori.com

Type 278 Kalau Anda Ingin Sukses ANDA JANGAN . Sumber Gambar : pastipuass.wordpress.com